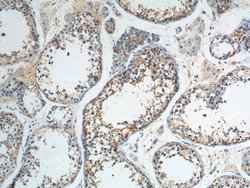
SNAPIN Rabbit anti-Human, Mouse, Rat, Polyclonal, Proteintech 20 &mu;L;

missing translation for 'onlineSavingsMsg'
Learn More
Learn More
SNAPIN Rabbit anti-Human, Mouse, Rat, Polyclonal, Proteintech
Rabbit Polyclonal Antibody
Brand: Proteintech 10055-1-AP-20UL
This item is not returnable.
View return policy
Description
This antibody can recognize the 15-18 kDa (Monomer) and 30-36 kDa (Dimer) forms of SNAPIN.
The protein encoded by this gene is a coiled-coil-forming protein that associates with the SNARE (soluble N-ethylmaleimide-sensitive fusion protein attachment protein receptor) complex of proteins and the BLOC-1 (biogenesis of lysosome-related organelles) complex. Biochemical studies have identified additional binding partners. As part of the SNARE complex, it is required for vesicle docking and fusion and regulates neurotransmitter release. The BLOC-1 complex is required for the biogenesis of specialized organelles such as melanosomes and platelet dense granules. Mutations in gene products that form the BLOC-1 complex have been identified in mouse strains that are models of Hermansky-Pudlak syndrome. Alternative splicing results in multiple transcript variants.Specifications
| SNAPIN | |
| Polyclonal | |
| Unconjugated | |
| SNAPIN | |
| SNAP associated protein, SNAP25BP, SNAPAP, SNAPIN | |
| Rabbit | |
| Antigen Affinity Chromatography | |
| RUO | |
| 20615, 23557, 295217 | |
| -20°C | |
| Liquid |
| Immunocytochemistry, Flow Cytometry, Immunohistochemistry (Paraffin), Immunoprecipitation, Immunofluorescence | |
| 0.35 mg/mL | |
| PBS with 50% glycerol and 0.1% sodium azide; pH 7.3 | |
| O95295, P60192, Q9Z266 | |
| Snapin | |
| SNAPIN Fusion Protein Ag0101 | |
| 20 μL | |
| Primary | |
| Rat, Mouse, Human | |
| Antibody | |
| IgG |
Product Content Correction
Your input is important to us. Please complete this form to provide feedback related to the content on this product.
Product Title
Spot an opportunity for improvement?Share a Content Correction